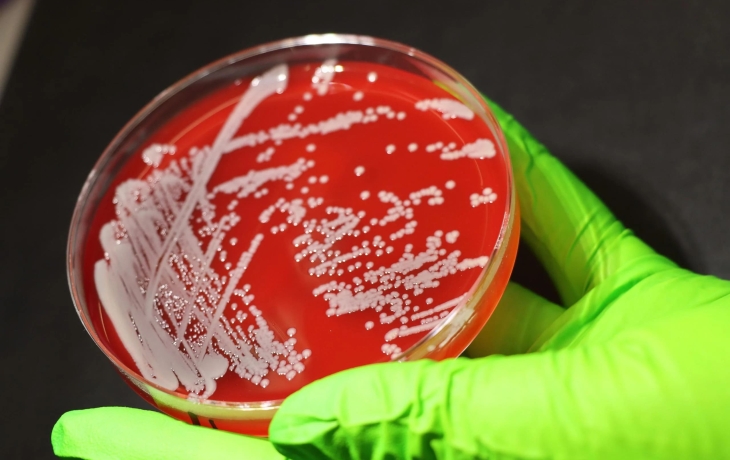
Генетики разгадали секреты выживания устойчивой к антибиотикам бактерии

Отима · Новости со всего мира
Власти Приднестровья в связи с энергетическим кризисом развернули свыше 30 пунктов обогрева и временного размещения граждан, способные принять более 1,3 тысячи человек, сообщили в МВД республики...
Российский боксер Артур Нагапетян 31 января в Москве проведет 8‑раундовый бой за пояс чемпиона Европы по версии IBA в весе до 51 кг с испанцем Самуэлем Кармоной в рамках турнира «Ночь чемпионов IBA»..
Нападение на газопровод «Турецкий поток» следует рассматривать как посягательство на суверенитет стран Европы, заявил министр иностранных дел и внешнеэкономических связей Венгрии Петер Сийярто в Fac..
Бывший футболист сборной России Александр Мостовой считает, что после возвращения в Москву бывший главный тренер «Спартака» Гильермо Абаскаль может занять различные нефутбольные должности...
Атака украинского дрона на компрессорную станцию «Турецкого потока» под Краснодаром вызвала обеспокоенность Еврокомиссии, заявила на брифинге представитель ЕК Анна-Каиса Итконен...
Бывший министр иностранных дел Дмитрий Кулеба Украины не дал сыну отправиться на фронт, а Грузию при этом пытался втянуть в конфликт с Россией, заявил мэр Тбилиси Каха Каладзе...
«Сибиряк» проведет три домашних матча без зрителей, два из которых условно, после инцидента с оскорблением игрока «Норильского никеля» Нандо в матче чемпионата России по футзалу, сообщается на офици..
Международная группа генетиков впервые изучила эволюцию золотистого стафилококка в естественной среде...
Власти Украины ведут военных на верную гибель, заявил в интервью журналисту Сергею Любарскому списанный после ранения украинский военнослужащий Юрий Корсунов...
Защитник ЦСКА Данил Круговой заявил «Матч ТВ», что у армейцев подобран хороший состав для борьбы за чемпионство в МИР РПЛ...
Размещение на Украине баз с ракетами малой дальности может послужить в качестве гарантий безопасности, заявил советник главы офиса президента страны Михаил Подоляк...
Китайские спортсмены получили приглашение тренироваться на Сахалине, заявил глава Минспорта и президент ОКР Михаил Дегтярев...
В туалетах парламента Финляндии были найдены следы наркотических веществ после рождественской вечеринки, на которой присутствовали, в том числе, и финские депутаты, сообщает телерадиокомпания Yle...
Астрофизики из Университета Джонса Хопкинса и Нортумбрийского университета разгадали один из важнейших вопросов космологии — как электроны в космосе достигают экстремально высоких энергий...
Нехватка людских ресурсов для ведения боевых действий станет ключевой причиной, которая подтолкнет власти Киева к скорейшему прекращению огня, заявил порталу Wirtualna Polska бывший командующий сухо..